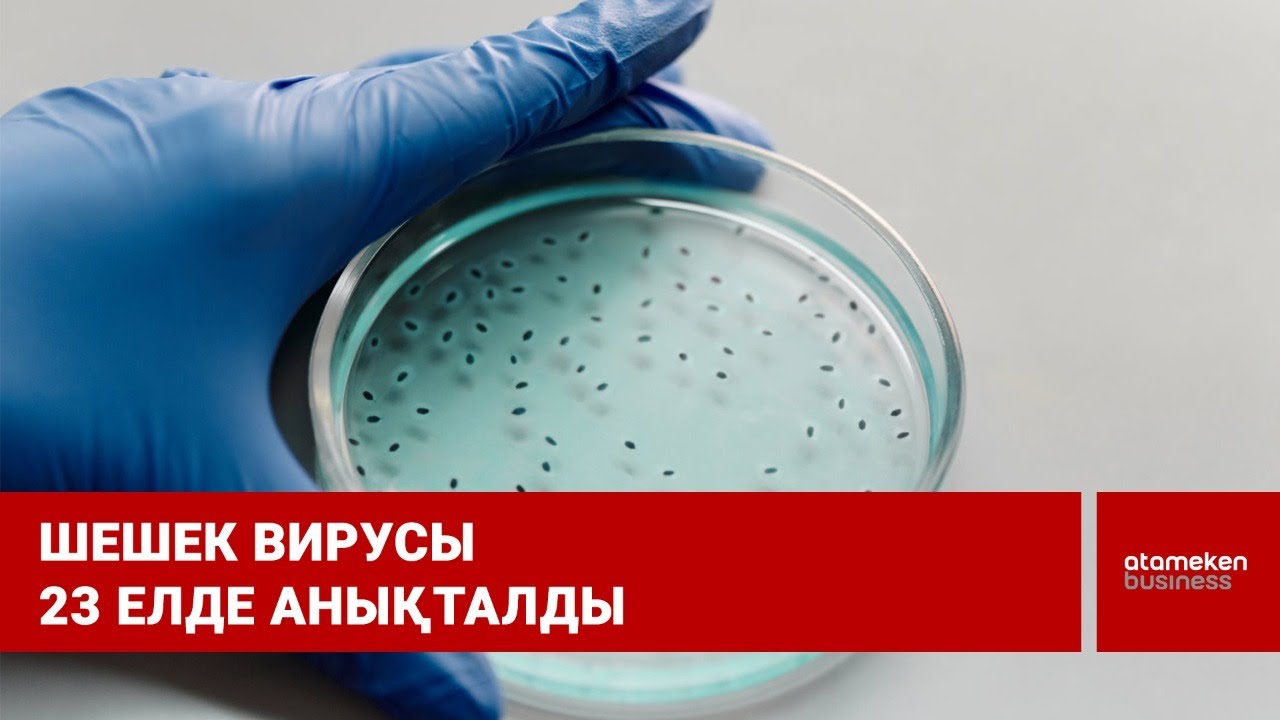

Мерзімді баспасөз басылымын, ақпараттық агенттікті және желілік басылымды есепке қою, қайта есепке алу туралы №17614-АА куәлік Қазақстан Республикасы Инвестициялар және даму министрлігінің Байланыс, ақпараттандыру және ақпарат комитетімен 2019 жылдың 15 наурызында берілді.
Отандық теле-, радиоарнаны есепке қою туралы №KZ23VJB00000123 куәлік Қазақстан Республикасы Инвестициялар және даму министрлігінің Байланыс, ақпараттандыру және ақпарат комитетімен 2016 жылдың 8 қыркүйегінде берілді.
Материалдарды пайдалану туралы келісім